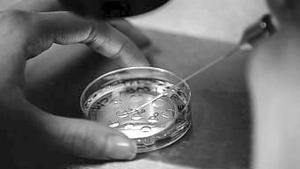

Más leídas
Actualidad | Pág. 3
Fiscalía abre indagación por eventuales coimas y Eguiluz entrega antecedentes

Actualidad | Pág. 3
Apoderados protestan contra Sistema de Admisión Escolar
Actualidad | Pág. 3
Mendoza responde por declaración en Fiscalía

Tendencias | Pág. 17
Dos proyectos liderados por chilenas reciben WSA Awards

Tendencias | Pág. 17
Controversia causa el posible cambio genético a dos bebés en China
Actualidad | Pág. 4
Remodelación del puente Esmeralda
Actualidad | Pág. 7
Denuncian falta de atención siquiátrica en Servicio Médico Legal de Concepción
Actualidad | Pág. 7
Funcionarios públicos marchan en segundo día de movilización

Actualidad | Pág. 7
Realizarán jornada para concientizar sobre enfermedad

Economía | Pág. 10
Presupuesto va a Comisión Mixta tras rechazo a recorte en gastos reservados

Economía | Pág. 10
Trabajadores de Puerto Lirquén apoyan programa de mentorías
Economía | Pág. 10
la norma
Deportes | Pág. 13
Región engrosa selección de canotaje en Sudamericano
Deportes | Pág. 13
Castillo: "Estamos en deuda con el pueblo aurinegro"
Economía | Pág. 11
BancoEstado realizó feria de educación financiera
Nacional | Pág. 8
Sesión por La Araucanía se suspende tras caer Ministro
Nacional | Pág. 8
El juez Carroza celebra la decisión de México de extraditar a Escobar Poblete
Nacional | Pág. 8
Los asesores legales de "Emilio" acusan "manipulación" y "persecución política"
Nacional | Pág. 8
El programa de asistencia exterior
Deportes | Pág. 15
UdeC ya tiene programación para cuartos de final
Deportes | Pág. 15
El Team Chile de patín carrera se trajo ocho medallas desde México
Deportes | Pág. 15
Chile va al Dakar con 17 pilotos
Deportes | Pág. 15
Niemann sonríe: recibe Mercedes de regalo
Internacional | Pág. 9
May: Reino Unido y EE.UU. ya trabajan acuerdo post "brexit"
Tendencias | Pág. 16
Concurso de innovación social invita a votar los proyectos

Tendencias | Pág. 16
Expertos se unen en el desafío de hacer ciencia colaborativa

Deportes | Pág. 14
Encuentro de Psicomotricidad: alistando el camino a la Básica
Página del lector | Pág. 21
Deficiente reparación de veredas
Espectáculos | Pág. 24
Cantautor José González despierta interés en el público local
Espectáculos | Pág. 24
Feria del Libro Antiguo y de Colección es un atractivo para los buenos lectores
Espectáculos | Pág. 24
"Verdades ocultas" también estará en el horario "prime"
Espectáculos | Pág. 23
Colectivo de danza butoh mira la esencia mapuche en "Püllü"
Espectáculos | Pág. 23
Se estrena película animada inspirada en Colonia Dignidad
Portada | Pág. 1
Fiscalía indagará dichos sobre presuntas "coimas"